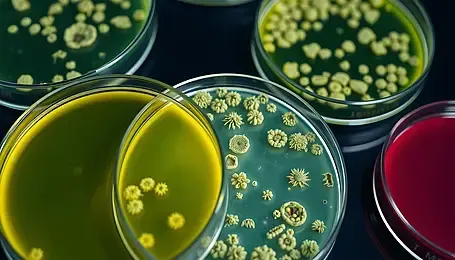
Global Reach

PIONEERING
NEW TECHNOLOGY
Our company specializes in developing new technology. Our top priority is to provide our clients with quality products and services that meet their needs.
We are proud of our experienced and professional team. Each member has their own expertise in different areas, which allows us to provide our clients with quality and efficient solutions.
We actively invest in research and development to stay at the forefront of emerging technologies, focusing on intellectual property protection to secure our position in the market.
100%
Innovation Focus
TOP
Quality Solutions